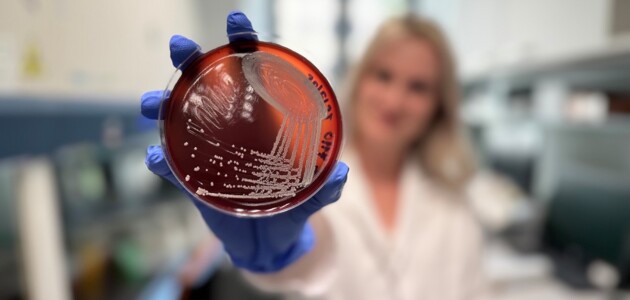

O nás
Chceš se stát součástí budoucnosti, kde se propojuje příroda, věda a technologie? Agronomická fakulta je tou správnou volbou. Zabýváme se moderní zemědělskou produkcí včetně precizního zemědělství, šlechtěním rostlin a technologií potravin, ale také aplikovanou technikou, zefektivněním léčby nádorových onemocnění nebo ekologií a změnou klimatu. Naši absolventi jsou odborníci na celou řadu aktuálních témat, která mění svět.
Studium tě nadchne nejen teorií, ale hlavně praktickými zkušenostmi. Naučíš se pracovat v moderních laboratořích plných prvotřídní techniky, ve sklenících, v terénu na školním zemědělském podniku nebo i v pivovaru či pekárně. Naše fakulta také disponuje vlastním chovem ryb, drůbeže a včel, masným a mlékárenským poloprovozem, referenční laboratoří bioplynových transformací nebo technickou zkušebnou pro měření parametrů osobních aut a traktorů. Navíc máme zcela nové zázemí pro molekulární biologii a biotechnologie, kde se věnujeme výzkumu léčby rakoviny nebo vesmírnému výzkumu.
Díky pevnému teoretickému základu a bohaté praxi získáš dovednosti, které ti otevřou dveře k zajímavým profesím – od profesionálního zemědělce, přes biotechnologa a výzkumníka, až po experta v potravinářství, ekologii nebo technice. Studium u nás ti umožní aplikovat znalosti v reálném světě se skutečným společenským dopadem.
Pojď s námi tvořit lepší a udržitelnou budoucnost a staň se odborníkem, který dokáže měnit svět kolem sebe!
✔️ Studium, které mění budoucnost
✔️ Špičkové zázemí
✔️ Moderní high-tech, ne muzejní kousky
✔️ Nejen teorie ale hlavně praxe
✔️ Úzký kontakt s vyučujícími
✔️ Kampus plný zeleně
✔️ Skvělý start kariéry i vlastního podnikání
✔️ A ano… máme i pivovar 🍺
Kde nás najdeš
Agronomická fakulta
Mendelova univerzita v Brně
Zemědělská 1
613 00 Brno
Přihlášky a přijímačky
- Elektronická přihláška: 600
Aktuality
Kontakt
Agronomická fakulta
Mendelova univerzita v Brně
Zemědělská 1
613 00 Brno